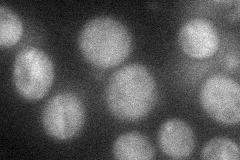
YPL028W
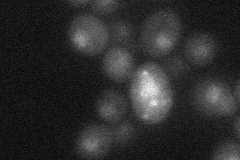
YPL028W

View description
Acetyl-CoA C-acetyltransferase (acetoacetyl-CoA thiolase), cytosolic enzyme that transfers an acetyl group from one acetyl-CoA molecule to another, forming acetoacetyl-CoA; involved in the first step in mevalonate biosynthesis
Localization:
Intensity:
Fold change:
Significance:
-
C’ GFP library in SD

nucleus170.78 -
N' NOP1pr-GFP in SD
cytosol34.34 -
N' TEF2pr-mCherry in SD
nucleus13.7976 -
N' NATIVEpr-GFP in SD

missing0 -
N' TEF2pr-VC and Cyto-VN in SD

#N/A0 -
C’ GFP library in SD+DTT

nucleus230.981.35No -
C’ GFP library in SD+H2O2

nucleus163.970.96No -
C’ GFP library in Starvation Media

nucleus194.61.13No -
C’ GFP library on the background of Pup2-DaMP

nucleus -
C’ GFP library on the background of CCT mutant

nucleus165.6530.969942No
